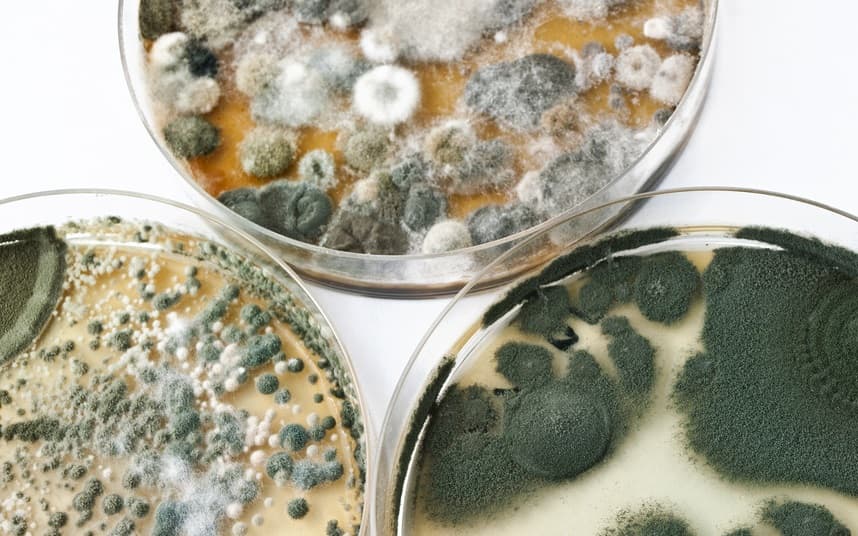

Как избавиться от плесени в ванной в домашних условиях
Специальные химические препараты обладают доказанной эффективностью, однако при этом они токсичны и зачастую стоят дорого. Если грибок только начал появляться, его можно вывести привычными средствами бытовой химии, более безопасными и недорогими.
В сети описано множество способов, как удалить плесень в ванной народными средствами. У многих есть недостатки. Они могут быть:
- Малоэффективны;
- Токсичны;
- Дорого стоить.
Ниже мы собрали самые доступные и эффективные народные средства от плесени в ванной. Также мы расскажем, как ими пользоваться.
Важно
Ни одно средство – не панацея. Есть много видов плесневых грибков, каждый из них устойчив к одному веществу и гибнет от другого. Если не получилось удалить плесень в ванной одним средством – попробуйте другое.
Почти всегда после очистки поряженного места остаются незаметные глазу «островки» выжившего грибка. При использовании любого средства и способа очистки повторите процесс через 30-60 минут!
Разные виды плесени в чашках Петри
Столовый уксус 9%
Для обработки используйте чистый флакон с распылителем. Залейте в него количество неразбавленной жидкости, исходя из размера пораженной площади. Распылите уксус на отмеченный участок до полного смачивания. Примерно через час, когда обработанное место высохнет, жесткой щеткой очистите поверхность, убирая остатки черной плесени.
Пищевая сода
В стакане теплой воды растворите 1 ст. л. порошка, хорошо перемешивая. Нанесите на пораженное место губкой или ветошью, добиваясь обильного смачивания. После полного высыхания обработанный участок хорошо вымойте чистой водой и вытрите насухо.
Раствор фурацилина
Для получения раствора нужной концентрации растертые таблетки (20 шт.) залейте стаканом теплой воды. После полного растворения заправьте средство в пульверизатор и распылите по поверхности заражения. Когда обработанное место полностью высохнет (примерно через 1 ч.), активно зачистите его жесткой щеткой или сухой ветошью.

Перекись водорода и борная кислота
Для получения нужного состава смешайте в пропорции 2:2:2:1 следующие ингредиенты
- Вода;
- Уксус столовый;
- Перекись водорода;
- Борная кислота.
Раствор хорошо перемешайте и кисточкой наносите на место заражения, добиваясь обильного смачивания. После высыхания промойте поверхность чистой водой и вытрите насухо.
Нашатырный спирт
Это средство применяют исключительно для гладких поверхностей: кафеля, керамики, стекла. Нашатырь разведите пополам с водой и протрите смоченной в растворе ветошью проблемные места. После высыхания промойте чистой водой. Во время работы обеспечьте хорошую вентиляцию в ванной.
Медный купорос
Для получения раствора нужной концентрации на 10 л воды возьмите 100 г купороса, тщательно размешайте. Пораженные поверхности обильно смочите кисточкой или ветошью, самые проблемные места обработайте особенно тщательно. Через 5-6 ч. обработанный участок хорошо промойте, высушите и проветрите.
Важно
Медный купорос высокотоксичен, поэтому при его применении пользуйтесь средствами индивидуальной защиты (респиратор, лчки, резиновые перчатки).
Хлорсодержащие препараты
Любые препараты с содержанием хлора – хорошие средства от черной плесени в ванной. Это может быть%
- Белизна;
- Доместос;
- Хлорный порошок;
- Хлор в таблетках.
На кафель, смесители, сантехнику нанесите хлорсодержащие растворы на 10 мин., после чего тщательно промойте чистой водой. Если поверхность пористая, обработайте ее из пульверизатора. Для пластика используйте 10% раствор белизны. Растворы с хлором также обладают высокой токсичностью.
Механический способ выведения грибка
Один из инструментов, который потребуется для удаления грибка механическим способом, это шпатель. Когда появляются черные точки на герметике в швах между плиткой в ванной комнате или на стенах в жилых помещениях, сначала нужно удалить пораженное покрытие. Для этого используют разные инструменты:
- шпатель;
- стальную щетку;
- насадку для шлифовки (устанавливается на дрель);
- острый нож и др.
Чтобы предотвратить распространение спор по воздуху (основной способ заражения поверхностей), облицовку нужно обработать водой. Для этого рекомендуется применять пульверизатор. Если использовать губку или ветошь, то часть спор попадет в воздух при соприкосновении материала с поверхностью. Когда грибок уже проник в структуру дерева или бетона, применяют метод фрезерной обработки. При сильном заражении плесень обнаруживается еще и на неорганических поверхностях
Если планируется бороться с ней самостоятельно, важно придерживаться инструкции:
- Поверхность смачивают водой из пульверизатора.
- Освобождают несущие конструкции от облицовки: обоев на стенах, побелки на потолке, напольного покрытия. Это позволит добраться до грибницы.
- Если оказалось, что плесень проникла глубже — в структуру материала несущей конструкции, снимают слой штукатурки. Нужно очистить стену до чернового основания — кирпичной кладки, бетона.
Против грибка можно применять и химические средства.
Как избавиться от плесени
При первом появлении незваной гостьи в доме нужно тщательно отмыть поверхность, которую она выбрала для своего расселения. Можно вывести плесень, как подручными средствами, так и антисептиками промышленного производства.
До того, как начать бороться с грибковым заражением, нужно соблюсти правила безопасности (средства очень агрессивные).
Для этого необходимо вооружиться следующими предметами:
- Резиновыми перчатками для исключения попадания рабочих жидкостей на руки.
- Респиратором (понадобится при обработке хлорсодержащими жидкостями).
- Щеточкой или кисточкой для нанесения состава.
- Емкостью для разведения концентратов.
- Очками нужно защитить глаза человека, который будет назначен, чтобы убрать черный грибок.
- Пульверизатор для нанесения раствора.
Черную плесень, появившуюся на потолке в ванной или в другом месте можно очистить с помощью нескольких народных средств.
Медный купорос
Нанести его можно только с помощью кисточки (не рекомендуется прямой контакт вещества с руками). На заводской упаковке указано подробное руководство к его применению. Это эффективное средство позволяет бороться с грибком уже после первого нанесения. Для проведения обработки в 10 литров воды добавляют 100 г купороса.
Хлорсодержащие жидкости
Избавиться при помощи раствора высокой концентрации чистящих средств на основе хлора (Доместос, Белизна, Санита для унитазов, отбеливатель отечественного производства) от грибка удастся полностью. Достаточно отмыть раствором грибок с поверхности, захватив при этом чуть больше площади, чем занимает пятно.
После проведения обработки помещение нужно хорошо проветрить для полного избавления от неприятного запаха, так как эти средства токсичны и могут оставить ожог на слизистой.
Чтобы обработать стыки между плиткой раствор должен быть достаточно концентрированным (пропорции 1:1 с водой). Наносится он пульверизатором, а потом обильно смывается чистой водой.
Масло чайного дерева
Эфирное масло этого растения будет отличным средством, чтобы вывести только что замеченное грибковое поражение поверхности. Достаточно пару ложек растворить в 0.5 л воды и нанести с помощью распылителя на загрязненную зону. Смывать раствор не нужно, а чтобы он подействовал, не принимайте ванну хотя бы 12 часов.
Сода и уксус
Такое средство годится для пораженных горизонтальных поверхностей. Чтобы исчезла черная плесень в ванной достаточно насыпать соду, а потом залить столовым уксусом. После оседания пены смойте остатки состава водой с мылом.
Рекомендуем: Избавляемся от мошек в комнатных цветах
Уксус, перекись и борная кислота
Вывести грибок поможет состав из воды (4 части), уксуса (2 части), перекиси водорода (2 части) и борной кислоты (1 часть). Хорошо смешать ингредиенты, и протереть ветошью, смоченной в составе, все пораженные плесенью места.
Антраценовое масло
Можно использовать только как профилактическое средство. Неприятно пахнет и требует проветривания после нанесения.
Бура
В 2,5 л воды всыпать 1 стакан буры. После очищения поверхности ванной комнаты нанести полученный состав, в смывании не нуждается, но нужно протереть поверхность сухой бумагой.
Камфорные шарики
Разложить шарики в помещении, в котором появились первые признаки грибкового заражения. Способ подойдет только в начале развития плесени в помещении. Если очаг поражения большой — потребуется более радикальные действия.
Антисептики
Если площадь поражения грибком невелика, то черноту нужно отскрести от поверхности, хорошо просушить это место, а затем нанести антисептик. Если избавиться сразу не удалось, то может понадобиться еще несколько обработок.
Если грибок въелся в поверхность, то полностью избавиться поможет только ремонт. Сначала избавляются от всей отделки в комнате, хорошо просушивают помещение. Дальше выполняются работы по нанесению антисептика с последующей штукатуркой и другими отделочными работами. В смеси рекомендуется добавлять тот же антисептик для повышения эффективности обработки или использовать такие составы, в которые антисептическое вещество добавлено на заводе.
Если у вас запущенный случай, то приобретая средство-антисептик убедитесь, что оно именно борется с грибком, а не препятствует его появлению.
Топ-3 специализированных средств
Эффективные антисептики, способные победить грибок, можно найти на полках хозяйственных магазинов. Они представлены:
- в баллончиках,
- канистрах,
- флаконах с распылителем.
Применение любых специализированных средств от плесени на стенах возможно только при строгом соблюдении инструкции.
Олимп стоп плесень
Популярное средство, разрешенное к использованию внутри жилых помещений. Владельцы домашних животных могут не беспокоиться — состав не опасен.
Веществом обрабатывают поверхности из:
- кирпича,
- дерева,
- камня,
- стены, покрытые краской и штукатуркой.
Средняя цена: не более 400 рублей за 5 литров. Средство представлено и во флаконе объемом 1 л стоимостью чуть более 100 рублей.
Dali
Универсальный антисептик, который разрешено использовать на любых поверхностях. Расходуется экономично благодаря флакону с насадкой-распылителем, отлично впитывается.
Несмотря на то, что средство не содержит хлора, из-за едкого запаха его рекомендуется использовать только в хорошо проветриваемых помещениях. Канистра объемом 6 литров стоит 580 р, флакон 0,6 л — 170 р.
Alpa Fongifluid
Антисептик, который представлен в уже разведенном виде. Он эффективен при обработках как внутри помещения, так и снаружи. Используют в расчете 1 л на 5 квадратных метров. Цена двухлитровой канистры — около 600 р.
Народные методы борьбы
Как только первая форма появляется на стенах, она должна быть немедленно удалена. Для этого используются не только методы хранения, но и народные методы. Во время процедур не забывайте о мерах безопасности, поэтому вы должны носить перчатки, защитную одежду и маску или респиратор.
Kreozot
Чтобы справиться с серьезной концентрацией, вы можете использовать креозот. Это агрессивное вещество должно быть растворено в спирте или масле и обработано пораженным участком. Остатки желтоватой массы должны быть удалены, поскольку они представляют опасность для здоровья. Креозот можно использовать только для бетонных и кирпичных поверхностей, но в случае деревянных панелей вам нужно найти другие средства.
уксус
Когда в ванной появляется плесень, многие не знают, что делать. Сначала нужно оценить масштаб предстоящей работы. Если изменения не очень глобальные, вы можете использовать обычный уксус, который используется в кулинарных целях. Обработка должна выглядеть так:
- протрите пораженный участок уксусом и дайте ему полностью высохнуть;
- кисть;
- Тщательно очистите очищенный участок водой.
- Уксус, который есть в доме почти у каждого, способен уничтожить огромное разнообразие микроорганизмов.
Нельзя выносить плесени в ванной комнате, слишком большой риск для здоровья человека. Регулярный контакт с грибком может привести к тяжелым хроническим кожным и респираторным заболеваниям.
ВНИМАНИЕ! Для того чтобы профессионально уничтожить грибок, советуем обратиться в ДЕЗЦЕНТР-РУС. Они используют инновационный метод сушки микроволновых стенок от плесени. Что позволяет избавиться от плесени навсегда! Гарантия 3 года !
В статье описаны наиболее эффективные способы избавления от плесени в ванной комнате при фугах в домашних условиях.
Лучше использовать этот метод на начальном этапе сразу после выявления проблемы, пока форма не проникнет прямо под пластину.
Как вы сами удаляете плесень в ванной комнате в плиточных прудах дома, не дожидаясь, пока опасный грибок поразит всю поверхность ванной комнаты?
Очистка поверхности
Очень хорошо, стараясь не повредить внешний вид плитки , нужно пройтись тонкой наждачной бумагой по всем швам, а затем тщательно смыть грязь и плесень с поверхности.
Этот метод хорош тем, что он экологически чистый, абсолютно безопасный и требует минимальных финансовых затрат. Однако он не гарантирует 100% удаления поврежденной пластины : наждачной бумагой можно удалить только верхний слой раствора.
Если грибок проникает глубже, необходимо тщательно очистить швы от вредного налета, возможно, вам придется полностью очистить закваску.
Глубокая уборка дома
Более радикальный и надежный метод борьбы с плесенью требует больше времени и усилий . Удалите раствор с швов с помощью отвертки или другого острого предмета.
Вы должны действовать осторожно, чтобы не повредить край плитки. Даже если весь раствор не может быть удален, все же желательно очистить шов как можно глубже. Очищенную поверхность следует обработать противогрибковым средством (можно купить в магазинах или хозяйственных магазинах) или обычным уксусом и дать высохнуть. Затем разбавьте новый раствор и нанесите резиновый шпатель на промежутки между плитками
Очищенную поверхность следует обработать противогрибковым средством (можно купить в магазинах или хозяйственных магазинах) или обычным уксусом и дать высохнуть. Затем разбавьте новый раствор и нанесите резиновый шпатель на промежутки между плитками.
Помните, что раствор быстро густеет, поэтому лучше приготовить небольшое количество смеси, при необходимости ее можно еще разбавить.
- Раствор должен высохнуть, после чего его следует удалить слегка влажной тканью или губкой. Не будьте слишком нетерпеливы, просто протрите плитку, как при обычной уборке.
- После того, как в течение дня раствор полностью высохнет, обработайте всю поверхность противогрибковым грунтом с глубоким проникновением.
Причины появления в доме
Размножение грибка на стене
Поверхности в доме или квартирах могут плесневеть по разным причинам:
- Повышенная влажность воздуха, свыше 70%. Чаще всего на лоджиях, балконах и ваннах комнатах, где и заводится грибок в первую очередь
- Недостаточное утепление стен, из-за чего они зимой промерзают, а потом оттают и становятся влажными, создавая идеальную микрофлору для развития спор
- Неправильная изоляция чернового пола (особенно в частных домах). Именно поэтому рекомендуется делать стяжку и «теплый пол», чтобы забыть о сырости и плесени
Споры могут попасть в квартиру через воду, воздух, людей или животных. Если для их развития микрофлора неблагоприятная, то стены не зацветут. Но если же в доме влажно и сыро, то грибок обязательно найдет себе укромное место в углу или на потолке и начнет интенсивно развиваться.
Зимой, когда стекло потеет, с него стекает конденсат и внизу на подоконнике собирается влага, из-за которой часто появляется плесень
Они любят штукатурку, обои, плитку, камень, заводятся на стыках кафеля
Основные признаки – образование черных и серых пятен. Запах плесени сырой, напоминающий амбре из погребов.
Важно определить причину и ее убрать, иначе борьба с грибковыми организмами будет неэффективной. Веранда пристроенная к дому – расширяем жизненное пространство: проекты, советы как создать своими руками (200 оригинальных фото идей)
Веранда пристроенная к дому – расширяем жизненное пространство: проекты, советы как создать своими руками (200 оригинальных фото идей)
Народные рецепты
Как вывести плесень в ванной комнате своими силами? В аптечке или на кухне наверняка есть вещества, способные эффективно бороться с грибком. Многие из них нам хорошо известны.
Используя их для уборки, можно не только добиться идеальной чистоты в помещении, но и надолго победить грибок.
Сода — безопасный домашний способ!
Инструкция следующая:
- Для приготовления раствора берут 1 ч. л. соды на 1 ст. воды.
- Полученным средством протирают места с пятнами.
- Смывать средство не нужно.
Этот способ является абсолютно безопасным для людей и животных. Раствор не имеет резкого запаха.
Уксус
Наносить это средство можно смоченной мочалкой или с помощью пульверизатора. Через час поверхность моют водой, а комнату хорошо проветривают.
Чтобы удалить плесень уксусом, придется сделать несколько еженедельных обработок. Работать лучше в перчатках.
Недостаток этого способа выведения грибка – резкий запах уксуса.
Перекись водорода
Это средство обладает отбеливающим эффектом, поэтому подойдет только для светлых поверхностей:
- Перед обработкой стены нужно отчистить от видимого грибка.
- Перекись с помощью губки наносят на подготовленную поверхность.
- Средство можно не смывать.
Нашатырь
Этот способ отлично подходит для выведения черных пятен с плитки, зеркал, стенок душевой кабины и других гладких поверхностей:
- Применяют нашатырь в разбавленном виде.
- Его смешивают с водой в пропорции 1:1.
- Раствор распыляют пульверизатором, оставляют на зараженных грибком поверхностях на 60 мин и смывают водой.
Недостаток способа – едкий запах нашатырного спирта, который может вызывать головную боль.
Бура
Это один из самых безопасных и эффективных противогрибковых препаратов.
Чтобы почистить стены:
- Стакан буры разводят в 2,5 л воды.
- Щеткой раствор наносят на все зараженные поверхности в ванной.
- Смывать средство не надо. Оно послужит хорошей защитой от дальнейшего размножения плесени.
Масло чайного дерева, лаванды, грейпфрутовых косточек, розмарина
Каждое из этих масел является природным антисептиком:
- Масло чайного дерева. Чтобы добиться нужного эффекта, чайную ложечку масла чайного дерева разводят в стакане воды. Средство распыляют на все поверхности и не смывают.
- Масло лаванды смешивают с водой в другой пропорции. На 1 стакан воды нужно всего 10 капель лавандового масла. Наносят и не смывают.
- Другие масла. Готовят рабочий раствор из масла розмарина или масла грейпфрутовых косточек по рецепту выше и наносят на пораженные участки.
Этот способ не подойдет людям, у которых есть аллергия на данные эфирные масла.
Марганцовка
Марганцовка легко справится с грибком на стенах. Раствор чайной ложки перманганата калия и 1 л воды будет иметь темно-розовый цвет, поэтому он подойдет не для всех поверхностей.
К достоинствам этого средства можно отнести:
- отсутствие резкого запаха;
- простоту в применении.
Раствор с поверхностей смывать не нужно.
Лимонная кислота
Рецепт простой:
- В стакан воды добавляют чайную ложку лимонной кислоты или свежевыжатого лимонного сока.
- Наносят на все поверхности с грибком и рядом с ним.
- Средство не смывают.
Кислота не даст грибку распространяться. Это средство отлично очистит плитку и придаст ей блеск.
Смесь из воды, перекиси, уксуса и борной кислоты
Каждый компонент этого средства легко справится с плесенью, а все вместе они дадут непревзойденный результат при обработке всех видов поверхностей.
Для получения рабочего раствора берут:
- 4 столовые ложки воды;
- 2 столовые ложки перекиси;
- 2 столовые ложки уксуса;
- 1 столовую ложку борной кислоты.
Смесь распыляют на зараженную плесенью поверхность.
Убираем плесень в ванной смесью уксуса, перекиси, борной кислоты и воды:
Сода с уксусом
Если натереть поверхность содой, а затем опрыскать уксусом, то это поможет вывести плесень и осветлить пятна от нее:
- Сначала усиленно втираем соду на зараженные участки.
- Затем опрыскиваем уксусом.
- Через 40 минут — час смываем водой.
- Повторяем через 1-2 дня.
Виды чёрной плесени
Аспергилл – это большой род микроорганизмов, имеющий несколько видов. Каждый из них можно отнести к чёрной плесени, но места их появления и степень воздействия на человека будут различны.
- Белая грибница с чёрными спорами. Встречается в туалетах, поражает пищу. Токсична, способствует простудам, аллергическим реакциям и даже онкологическим заболеваниям.
Аспергилл дымящий. Присутствует на повреждённых овощах, фруктах, зерне. Споры проникают в организм, где поражают эритроциты и сильно снижают иммунитет.
- Улокладиум. Обитает в матрацах, простынях, туалете. Может провоцировать кандидоз, вагинит, болезни почек и печени. Коварство грибка в «незаметности» — анализы часто не показывают его наличие в организме.
Кладоспориум («керосиновый гриб»). Поражает обширный круг предметов: пищу, рамы окон, землю (домашние растения), бытовую технику (холодильник), средства для ухода за лицом и руками, одежду, стены домов, ГСМ. Способствует развитию сильной аллергии в любом возрасте, поражения кожи (экзема, дерматит).
- Чёрная грибница с белыми спорами («чёрная гниль»). Любит деревянные или оштукатуренные поверхности, но в жилых домах практически не встречается.
Пенициллиум. Появляется преимущественно в продуктах: зерне, крупах, кураге, черносливе, кофе. Споры грибка опасны для детей – они резко подавляют иммунитет за счёт вредоносного вещества охратоксина.
- Хетомий. Может появиться и начать размножаться на любой поверхности. Опасен, если попадёт внутрь человека (с пищей): вызывает отравление, при тяжёлом течении которого есть вероятность летального исхода.
Альтернария. Имеет не только чёрный, но и серый оттенок. Возникает на порченых фруктах, овощных и зерновых культурах, прелой листве, мясе. От контакта со штаммом этих грибов человек может ожидать появления зуда, насморка, дерматита и тяжёлой астмы.
- Wallemia sebi — грибок, не любящий влагу, напротив, предпочитает сухость и тепло. Вывести сложно, однако опасности для человека не представляет.
5 важных советов по профилактике
Поборов плесень в ванной, важно не допустить его повторного появления. Для этого рекомендуется взять на вооружение следующие правила:
Наладить в ванной комнате хорошую циркуляцию воздуха.
После водных процедур и стирок все мокрые поверхности следует насухо вытирать
Особое внимание должно уделяться стыкам, щелям и другим местам, в которых скапливается влага.
Не следует допускать скопления мокрых вещей в ванной, в том числе с целью просушки. Следует устранить все источники повышенной влажности в помещении.
Периодически во время уборки в ванной нужно протирать герметик уксусом или его водным раствором.
Стены, пол и потолок не должны содержать трещины
Все имеющиеся дефекты поверхностей должны быть устранены.
Плесень может разрастаться не только на герметике. Кроме него грибком часто поражаются также другие поверхности, вплоть до душевых шторок.
Причины появления черной плесени
Идеальные условия для появления и размножения грибка – влажность и тепло. Для обоих этих условий ванная – лучшее место. Заражение происходит очень просто: базовые споры могут содержаться в строительных смесях, на инструментах рабочих, но чаще всего попадают через вентиляцию.
Какие факторы способствуют черной плесени в ванной комнате?
Повышенная влажность
Она формирует благоприятную питательную среду для микроорганизмов. В первую очередь, это конденсат, который проникает в плохо изолированные трещины между плитками, в пористую поверхность стен и потолка (если они покрашены или оклеены обоями).
Отсутствие ультрафиолета
Прямой солнечный свет – главный враг грибка. Однако далеко не все квартиры могут похвастаться наличием окон в ванной, для северных широт проблема становится более острой из-за малой годичной инсоляции.

Плохая вентиляция
Теплый влажный воздух может задерживаться в ванной по разным причинам. Наиболее частая – засорение вентиляционной шахты или ошибки при проектировании и строительстве. Это одна из самых распространенных причин появления плесени.
Отсутствие спецобработки
Если при строительстве или ремонте не применялись антисептики, то грибок рано или поздно появится с вероятностью, приближающейся к 100%. А если учесть, что специальные составы (или включение особых веществ в отделочные материалы) стали применяться относительно недавно, и не все застройщики включают их в отделку, то такая обработка становится обязательной для всех квартир и домов.
Радикальные средства от плесени
Один из самых радикальных методов – капитальный ремонт, который подразумевает следующее:
- освобождение стен от кафельной плитки, обоев или другого вида отделочных материалов;
- замена напольного покрытия;
- удаление побелки с потолка.
Все очищенные поверхности должны тщательно просохнуть в течение двух-трех суток. В это время воздух в комнате должен оставаться сухим, поэтому стоит воздержаться от посещения ванной.
Однако этого недостаточно, так как споры уже успели проникнуть в структуру строительных материалов. Чтобы уничтожить их можно воспользоваться специальными антисептическими составами или самостоятельно приготовленными средствами. После того, как плесень будет устранена, можно приступать к отделочным работам.
Обработка стен перед отделкой
Чтобы черная плесень больше не появилась в отремонтированной комнате, следует позаботиться о надлежащем проветривании. При необходимости можно заменить дверь в ванную на модель, оснащенную вентиляционными отверстиями.
Как удалить грибок в ванной комнате?
А что же предпринять, если плесень уже обосновалась в ваших пенатах и нахально захватывает жизненное пространство? Переходим к боевым действиям! Методика будет зависеть от того, где именно образовался грибок. Итак, разберемся, как вывести грибок в ванной.
На кафеле
Местом для поселения грибок обычно выбирает швы между плитками, поэтому их целесообразно обрабатывать водоотталкивающими затирками.
Если колония еще не успела развиться, ее достаточно счистить ножом, а пораженное место – обработать любым химсредством для мытья сантехники.
Эффективно воздействуют на плесень любые составы с содержанием хлора. Таковыми являются всевозможные отбеливатели, а также средства для чистки унитаза – Доместос, Комет, Санита и др.
Только необходимо помнить, что хлор представляет опасность и для человека, поэтому пользоваться этими средствами необходимо в защитных очках и распираторной маске. Обычно моющее вещество растворятся в малом количестве воды (пропорция — в соотношении 1:1), а после применения очень тщательно смывают
Если грибница успела разрастись и глубоко внедриться в стену, лучше вызвать специалистов. Сотрудники дезинфекционной службы используют креозот, а также такие мощные методы, как ионизация и санация. С помощью особого агрегата в зону развития плесени подается воздух, насыщенный микроэлементами и ионами, после чего колонии микроорганизмов исчезнут бесследно.
На потолке
Рассмотрим, чем вывести грибок в ванне на потолке. Небольшие очаги также можно опрыскать «Белизной» или любым другим хлорсодержащим препаратом.
Подойдет и любой из описанных выше антисептиков.
Выбирая антисептик, убедитесь, что он предназначен именно для уничтожения плесени, а не для профилактической обработки поверхностей.
Эффективным средством является и раствор медного купороса, который готовится в соотношении 1:100. На окрашенном потолке медный купорос лучше не использовать:он может оставлять некрасивые пятна.
Разросшуюся на потолке плесень приходится удалять вместе с побелкой и штукатуркой. Перед тем как взяться за шпатель, пораженный участок лучше смочить – пыли в этом случае образуется меньше.
Бетонную плиту и швы следует щедро обработать любым из описанных выше антисептиков, затем (после высыхания) нанести на нее обычную проникающую грунтовку. После оштукатуривания и нанесения шпаклевки поверхность обрабатывается антисептиком повторно, после чего окрашивается или белится. Разумеется, в штукатурку или краску также необходимо добавлять антисептик.
Перед побелкой потолка в раствор извести можно добавить тот же медный купорос. Он придаст смеси приятный голубоватый оттенок.
Перманганат калия
Если химическое название ни о чем не говорит, то вот слово «марганцовка» наверняка известно всем и каждому. Еще совсем недавно ее активно добавляли даже в воду для купания младенцев. Это делалось с целью ее обеззараживания, и перманганат калия действительно обладает дезинфицирующими свойствами.
Однако сегодня педиатры не рекомендуют применять марганцовку. В первую очередь по той простой причине, что она совершенно не безобидна. Тем не менее, это действительно хороший дезинфектант. И, в том числе, перманганат калия может уничтожать грибки.
Правда, загвоздка в том, что марганцовку сегодня не купить. Если же она осталась дома с незапамятных времен, почему бы не почистить ею ванну от плесени. Для получения желаемого эффекта надо приготовить весьма крепкий раствор. Это значит, что он должен быть насыщенного фиолетового цвета. Жидкостью сбрызгивают проблемные участки, затем протирают и смывают чистой водой.
Обратите внимание! Чтобы впредь не думать, чем обработать плесень в ванной, следует проверить систему вентиляции и наладить ее таким образом, чтобы воздух циркулировал: влажные воздушные массы беспрепятственно выходили, а на смену им приходили свежие. Дополнительно можно купить специальное устройство — осушитель воздуха
Такую же функцию выполняют брикеты древесного угля: они поглощают влагу, а вместе с ней и неприятные запахи. Зачастую приходится также утеплять помещение, так как плесень образовывается, когда из-за перепада температур появляется конденсат.

























































